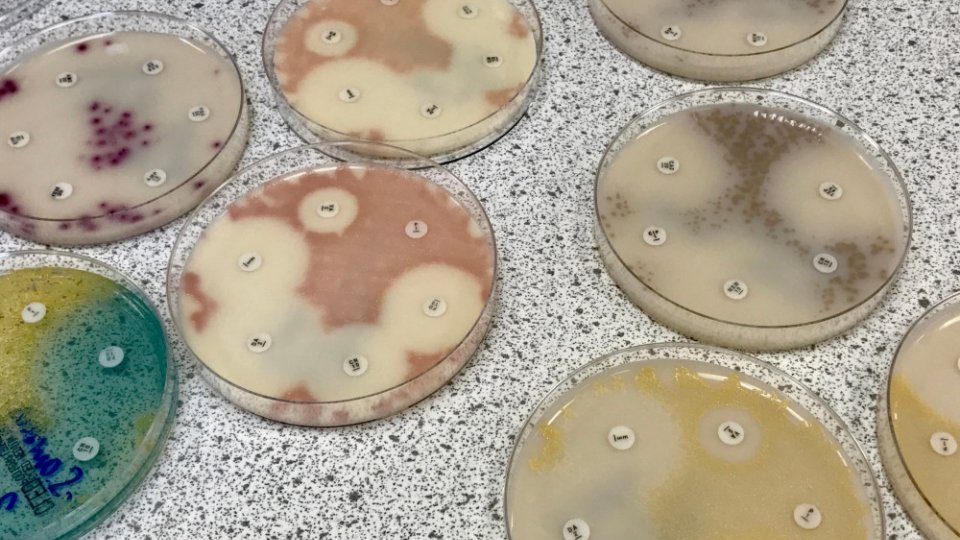
At a Glance

Encouraging Environmental Sustainability Through Art and Citizen Engagement

At a Glance
- Artist-driven interventions bring communities together around sustainability
- Using Art Technology Society Interactions (ATSI) to co-create environmental solutions
- Building a Community of Practice and digital repository of inclusive design tools

Empowering Community Creativity to Tackle Environmental Sustainability
Environmental challenges require more than technology, they need inclusive, culturally grounded engagement. VOICE disrupts traditional top‑down models by enabling artist-led projects that bring citizens and stakeholders into creative collaboration. Through artistic interpretation, community dialogue, and digital innovation, VOICE promotes shared ownership of sustainability solutions, better reflecting diverse voices and local needs.

Co-creating Sustainability Through Art, Dialogue, and Shared Experiences
VOICE brings together artists and communities to find new ways of addressing local environmental and societal challenges. At the heart of the project are creative initiatives led by artists, who work directly with citizens to understand their concerns and ideas. These collaborations use artistic practices to explore problems and imagine solutions, blending culture, technology, and local knowledge. VOICE supports these activities with mentoring and training, helping artists and participants build skills and confidence. The results of these collaborations, including methods, stories, and creative outcomes, are shared on a digital platform to inspire others and support further innovation. In this way, VOICE strengthens community resilience, promotes inclusive innovation, and helps drive local environmental action.
